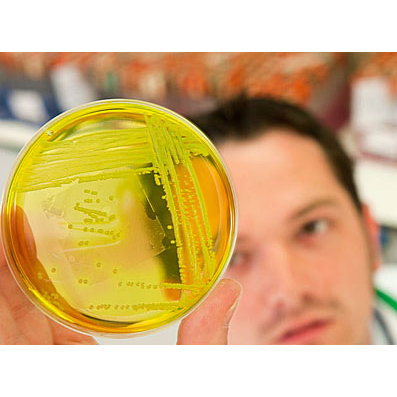

ดำเนินงานครบรอบ 35 ปี





แจ้งปัญหา ร้องเรียน ติชมบริหาร สมัครงานหรือสอบถามข้อมูลอื่นๆ กรุณาคลิกด้านล่างเพื่อกรอกข้อมูล
บริษัท กิบไทย จำกัด ก่อตั้งขึ้นเมื่อปี พ.ศ.2528 เราเป็นบริษัทแรกเราเป็นบริษัทแรก ๆ ที่ดำเนินธุรกิจ เป็นตัวแทน จำหน่ายผลิตภัณฑ์น้ำยาและเครื่องมือ สำหรับงานวิจัยทางวิทยาศาสตร์ ชีวภาพ ให้แก่ มหาวิทยาลัย, สถาบันวิจัย, หน่วยงาน ทั้งภาครัฐและเอกชน รวมถึงโรงงานอุตสาหกรรมต่างๆ
จากความเชื่อถือและการยอมรับที่ได้รับจากทุกฝ่าย ทำให้วันนี้ กิบไทย ดำเนินธุรกิจ ด้วยความมั่น คงยาวนานมาเป็นระยะเวลากว่า 37 ปี จนกลายเป็นแถวหน้าทางด้านเครื่องมือสำหรับ งานวิจัยทาง วิทยาศาสตร์ชีวภาพ เพื่อรองรับทุกความต้องการของลูกค้าให้ได้มากที่สุด
เราเป็นตัวแทน จำหน่ายสินค้ากว่า 70 แบรนด์จากทั่วโลก และยังรวมไปถึงการให้บริการ แบบครบวงจรเริ่มตั้งแต่ ฝ่ายบริการลูกค้า (Customer Service Center) ที่ให้บริการลูกค้า แบบเบ็ดเสร็จรวมศูนย์กลาง ไว้ที่เดียว เพื่อให้ลูกค้าได้รับความสะดวกสบายในการติดต่อกับบริษัท ศูนย์ฝึกอบรมกิบไทย (Gibthai Training Center) ที่ให้บริการฝึกอบรม ความรู้และเทคโนโลยีใหม่ๆ ในแขนงต่างๆ แก่ผู้สนใจทุกท่าน ไปจนถึงการบริการหลังการขาย ทั้งทางด้านเทคนิค (Technical Support) และทางด้านช่างบริการ (Technical Service) ให้ทุกท่านมั่นใจในการใช้ผลิตภัณฑ์ได้อย่างเต็มที่


" To be the most responsive distributor of biological reagents, reagent systems and apparatus used in research and diagnostic technology application in Thailand. The concept of responsiveness refers to customer support, and providing value in supporting and offering molecular biology and workshop nationwide."
นิเวศน์ ประยูรเธียร
ประธานผู้บริหาร

ผู้บริหารได้แสดงความมุ่งมั่นในการประยุกต์ใช้มาตรฐาน จึงกำหนดนโยบายคุณภาพของบริษัทฯ ขึ้น เพื่อเป็น ถ้อยคำในการแสดงความมุ่งมั่นและสื่อสารให้พนักงานทุกคนรับทราบถึงวัตถุประสงค์ ความต้องการ ความคาดหวังและเจตนารมณ์ในการประยุกต์ใช้ระบบบริหาร โดยกำหนดให้นโยบายคุณภาพนี้เป็นกรอบในการกำหนดการจัดตั้งวัตถุประสงค์คุณภาพ เป้าหมาย ตัวชี้วัดในการดำเนินการ และความต้องการของลูกค้า ซึ่งนโยบายคุณภาพ ของบริษัทฯ มีดังนี้
The company is committed to procuring, sourcing, and distributing life science products, cutting-edge laboratory equipment, and health and well-being solutions. Additionally, we provide training and after-sales services delivered by highly skilled professionals. We continuously develop and enhance quality standards to elevate customer confidence and satisfaction to the highest level.
เพื่อให้บรรลุถึงนโยบายที่วางไว้ บริษัทฯ มีแนวทางการบริหารงานเป็นวัตถุประสงค์ ดังนี้
จึงขอถ่ายทอดให้พนักงานทุกระดับ รวมถึง ผู้มีส่วนได้เสียร่วมกันทำความเข้าใจ นำไปปฏิบัติอย่างจริงจัง และต่อเนื่อง


ดำเนินงานครบรอบ 35 ปี

เปิดตัวแผนก Professional Diagnostics Division เพื่อรองรับ และให้บริการลูกค้าในส่วนงานโรงพยาบาล และห้องแล็บตรวจวินิจฉัยโรค

เปิดตัวแผนก Health & Aesthetics เพื่อรองรับและให้บริการลูกค้า ในกลุ่มสุขภาพ และความงาม

ดำเนินงานครบรอบปีที่30

ปรับปรุงและเปิดสำนักงานฝึกอบรมกิบไทย อ.หาดใหญ่ จ.สงขลา

เปิดสำนักงานสาขาภาคตะวันออกเฉียงเหนือที่ จ.ขอนแก่น เพื่อให้บริการลูกค้าในเขตภาคตะวันออกเฉียงเหนือ

อาคารสำนักงานใหม่แล้วเสร็จเพื่อรองรับการขยายตัวของฝ่ายขาย รวมทั้งปรับปรุง พื้นที่และอุปกรณ์อำนวยความสะดวกของศูนย์ฝึกอบรมกิบไทยใหม่ สามารถรองรับ ผู้เข้าร่วมประชุมได้ถึง 100 ท่าน

เปิดตัวแผนก Clinical Product Division เพื่อรองรับ และให้บริการลูกค้าในส่วนงานโรงพยาบาล และห้องแล็บ ตรวจวินิจฉัยโรค

เปิดตัวแผนก Industrial Market Division เพื่อรองรับ และให้บริการลูกค้าในตลาดอุตสาหกรรม
ดำเนินงานครบรอบปีที่ 25

สร้างอาคารคลังสินค้าใหม่ เพื่อเพิ่มพื้นที่การจัดเก็บสินค้า ที่มีขนาดใหญ่และอาคาร 3N Holding Mansion สำหรับเป็น ที่พักสวัสดิการให้กับพนักงานของบริษัท

ได้รับการรับรองคุณภาพมาตรฐานระดับสากล ISO 9000:2001 พร้อมปรับเปลี่ยน โลโก้บริษัทฯ เป็นรูปลักษณ์ใหม่ที่สื่อถึงแนวคิด 4Gs “GENIAL PERSON, GROUP WORKING, GREAT OUTPUT, GENUINE PARTNER”

ขยายเครือข่ายธุรกิจ เพื่อตอบสนองความต้องการของตลาด ได้อย่างทั่วถึง ภายใต้ชื่อกลุ่ม บริษัท 3N Holding Company อันได้แก่ บริษัท กิบไทย จำกัด และบริษัท ไปเปต ด็อกเตอร์ (ประเทศไทย) จำกัด เปิดสำนักงานสาขาภาคใต้ที่ อ.หาดใหญ่ จ.สงขลา ให้บริการครอบคลุมลูกค้าในเขตภาคใต้

ย้ายสำนักงานสาขาภาคเหนือมาอยู่ที่ถนนนิมมานเหมินทร์ในปัจจุบัน พร้อมก่อตั้ง ศูนย์ฝึกอบรมกิบไทย สาขาเชียงใหม่

ดำเนินงานครบรอบปีที่ 20

สร้างอาคารคลังสินค้าใหม่ เพื่อเพิ่มพื้นที่ในการเก็บสินค้าคงคลัง โดยมีระบบ การจัดเก็บและควบคุมอุณหภูมิในระดับต่าง ๆ ตามประเภทของผลิตภัณฑ์ตลอด 24 ชั่วโมง

เปิดสำนักงานสาขาภาคเหนือที่จังหวัดเชียงใหม่ ให้บริการครอบคลุมลูกค้าในเขตภาคเหนือ

เปิดตัว www.gibthai.com เว็บไซต์อย่างเป็นทางการของบริษัท

ก่อตั้งศูนย์ฝึกอบรมกิบไทยอย่างเป็นทางการ เพื่อนำเสนอ เทคโนโลยีใหม่ ๆ ในรูปของการประชุมเชิงปฏิบัติการ ทั้งภาค บรรยาย และ ภาคปฏิบัติ การที่ผู้เข้าร่วมประชุมจะได้ลงมือปฏิบัติ

ย้ายสำนักงานมาอยู่ที่อาคารกิบไทย ที่ถนนสุทธิสารวินิจฉัยในปัจจุบัน

ก่อตั้งบริษัทฯ ในเดือนกรกฏาคม ตั้งอยู่ที่อาคารมหาทุนพลาซ่า

